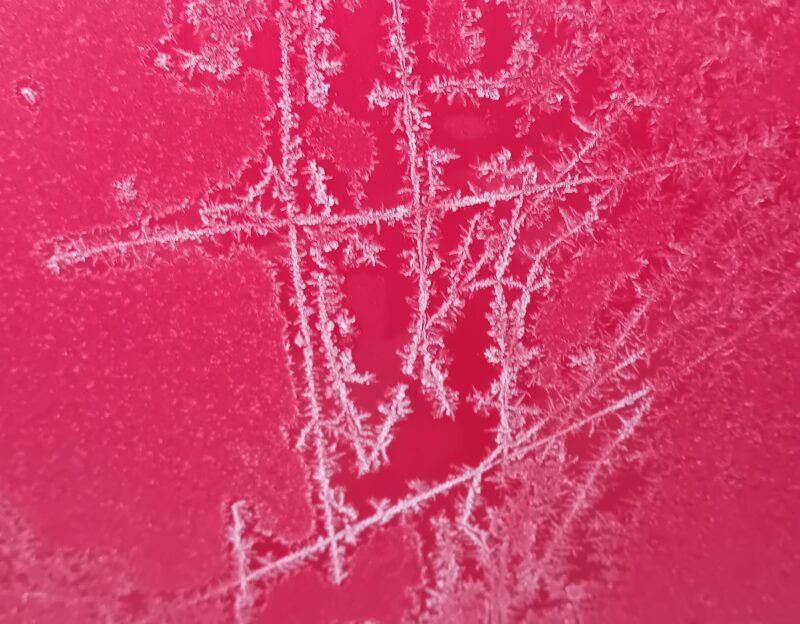

2.4.3.2 Diskreter Transport auf der Fläche am Beispiel der Eisblumen
Kann man verstehen, warum auf Glasscheiben und anderswo Eisblumen wachsen? Und kann man verstehen, warum sie manchmal eisfreie Flächen um sich haben?
Hier ein Beispiel vom Jahresende 2022:

Eisblumen auf der Frontscheiben-Innenseite des Autos
Eisblumen außen auf dem roten Lack.
Und nun ein kurioses „eingerolltes“ Eisblumenmuster auf dem Hut einer Grauen Nebelkappe am gleichen Oktober-Morgen 2025 in Morgenröthe-Rautenkranz:

Wir sehen:
- oben zweimal nadelbaumartige fast gerade Zweige mit parallelen Nadeln auf beiden Seiten, unten eingerollte Strukturen
- oben zwischen den Zweigen Flächen mit kleinen ungeordneten Nädelchen, unten einen glatten Eis-Zwischenraum
- oben einen eisfreien Zwischenraum zwischen beiden Strukturen, unten überall Eis (glatt und durchsichtig, darauf das Muster etwas erhaben)
Was am meisten verwundert (wenn man die Eisblumen als seit Kindheitstagen bekannt voraussetzt), ist der eislose Zwischenraum oben. Schließlich ist ja die gesamte Innenraumluft des Autos überall gleich feucht, wieso lässt sie da freie Flächen auf der Scheibe zu?
Es wird schnell klar, dass es also Prozesse geben muss, die nichts mit der Luft zu tun haben. Da bleibt nur eine Lösung: Es muss auf dem Glas der Scheibe selbst passieren: Entweder verdampft neben den Zweigen alles (klingt sehr unwahrscheinlich) oder aber es gruppiert sich um. Aber warum?
An anderen Stellen ist schon davon gesprochen worden:
Der Prozess besteht aus mehreren Schritten mit unterschiedlichen Abhängigkeiten.
1. Antransport
Die Wasserdampfmoleküle sind in der Luft. Je nach relativer Feuchte können sie Tröpfchen bilden, deren Mindestradius sich aus dem Gleichgewicht von Verdampfung und Kondensation bei bestimmter Oberflächenspannung (Materialkonstante) ergibt (das nennt sich homogene Keimbildung, bei der die Keime, einmal gebildet, weiter wachsen können, weil die Spannung mit wachsendem Radius abnimmt). Es kann aber auch heterogen vor sich gehen, wenn Fremdkeime vorhanden sind, in der Luft feine Stäube oder aber – und das ist der ideale Riesenkeim – glatte und ebene Flächen (also zum Beispiel Fensterglas) vorhanden sind, die eine gute Adhäsionskraft für Wasser aufweisen. Der Transport zu diesen Keimen verläuft bei ruhender Luft durch Diffusion, bei verwirbelter durch Konvektion. Dieser Transport hat eine gewisse Leistung, je nach dem Gradient des entsprechenden Potentials, hier der Konzentration („Luftfeuchte“).
2. Anlagerung an das Glas und Umgruppierung auf dem Glas
Der Anlagerungsprozess ist ein Netto-Ergebnis von Anlagerung und Loslösung (Adsorption und Desorption). Hier spielen Bindungs-Energien eine Rolle, die durch jedes einzelne Molekül mit dem Glas oder den Nachbarmolekülen bestimmt werden.
Man ahnt schon, dass man hier in die Tiefe gehen muss. Das „Springen“ von einer Glas-Stelle zu nächsten könnte zum Beispiel mit einer anderen Anregungsenergie erfolgen als das „Springen“ von Glas zu einem anderen Wassermolekül oder von Wasser zu Wasser. Und selbst für den festen Wasserzustand (Eiskristall) gibt es unterschiedliche Stellen zum „Andocken“ eines Wasser-Moleküls (das ja als solches weder flüssig noch fest ist):
– an einer Spitze des Kristalls
– an einer geraden Fläche (hier auch: Rand eines 2D-Kristalls)
– an einer konkaven „Innenspitze“ des Kristalls
Je nach Energie-Gewinn (Bindungsenergien unterscheiden sich bei diskreten Konfiguratinen wie den Kristallen je nach Lage) ist die Wahrscheinlichkeit des Andockens unterschiedlich:

Energiegewinn bei der Adsorption an unterschiedlichen geometrischen Konfigurationen einer geordneten Struktur
Das hat zur Folge, dass glatte Ränder entstehen können, bei quadratischen 2D-Elementen am Ende also Rechtecke (vgl. Überlegungen und Modellierungen unter 1.2.4 „Zweidimensionales zelluläres Formenwachstum analog den Kristallen“!)
Hier ist es nicht einmal die Frage, ab das Wassermolekül, das am Rande eines Eiskristalls andockt, direkt aus der Luft oder „von nebenan“ der Glasfläche kommt.
Verallgemeinert man das Prinzip noch weiter und differenziert schärfer, kommt man zu dem Ergebnis, dass große Kristalle auf Kosten von kleinen Kristallen wachsen können, da der Anteil an Außen-Ecken (als „ungünstige“ Andock-Plätze) bei großen in Bezug auf alle angebotenen Plätze kleiner ist als bei kleinen. Das beobachtet man tatsächlich auch in der Mineralogie, wenn die Übersättigung der Umgebung verschwindet, also kein Netto-Wachstum mehr stattfindet, sondern nur noch eine Umverteilung zwischen den Kristall-Individuen. (Das bedeutet außerdem, dass diese Prozesse beispielsweise in einem Granitfelsen nur sehr langsam stattfinden, wenn zum Beispiel durch langsame Felsbewegung durch Verringerung der Auflast (Verwitterung) Hohlräume entstehen, die sich mit Zersetzungsprodukten der Feldspate, nämlich Quarz und Calcit, in herrlicher Kristallform füllen.)
An der Glasscheibe im Auto geht das etwas schneller, und zwar so schnell (aber nicht ZU schnell), dass sich Spitzen bilden können, die der Diffusion entgegen wachsen, und die alles aus ihrer Umgebung „auflutschen“, ohne dass aus der dritten Dimension nachgeliefert werden kann (da ist vielleicht kein Überschuss mehr da?). Jede übliche Schneeflocke hat solche nadelförmigen „Dendriten“ (solange es nicht Starkfrost-Schnee in Form sechseckiger dünner Plättchen ist).
Das Frontscheiben-Foto ist also tatsächlich eine Besonderheit, denn das Angebot an Wasser-Molekülen war groß genug, um an der Scheibe niederzuschlagen, aber auch klein genug, um nicht alles zuzumüllen und den gefräßigen Kristallen zu ermöglichen, ihre Umgebung leerzufressen.
Ein ganz anderer Vorgang ist das Schießen von Eisnadeln auf einer komplett nassen Scheibe, die plötzlich von außen gekühlt wird (anfahrender Bus oder Zug bei starkem Frost und guter Innenheizung, hab ich als Student mal in einem Bummelzug nach jeder Station neu beobachten können: etwa 0,5 mm/s Spitzen-Wachstums-Geschwindigkeit; Farnblätter entstehen bei dickeren Schichten).
Auf dem Silbersee in der Dresdner Heide habe ich einmal meterlange Eisnadeln schwimmen sehen, da es völlig windstill war und die Temperatur genau stimmte. Die Zwischenräume fangen gerade an zuzufrieren. (Hier wird Wärmeenergie transportiert, nicht Wassermoleküle selbst!)

Meterlange Eis-Nadeln auf dem Silbersee in der Dresdner Heide bei Klotzsche
Auch das Eis auf einer Pfütze oder einer Wasserschale bildet solche Nadel-Strukturen, sogar mit 60°-Winkeln zu anliegenden dünnen Nadel-Reihen, was eindeutig auf die Einkristallinität hinweist:

Teilkristallisierte Wassseroberfläche einer flachen Schale in unserem Garten
FAZIT:
Es gibt erstaunlich viele Strukturen in unserer Umwelt, die eindeutig darauf hinweisen, dass sie als ein Ergebnis eines Prozesses enstanden sind, der sowohl mehrstufig als auch stark parameterempfindlich ist.
(Siehe auch das Thema „Rekristallisation“ unter: 2.4.3.8)
Übrigens: Ein nicht diskreter Transport (wäre dann isotrop, also richtungsunabhängig) würde zu keinen Ecken und Kanten führen können, sondern müsste kreisförmige Strukturen ergeben (z.B. Achat-Geoden, siehe Berechnungne in 2.5.1.2 Versetzungsfreiheit der Achatbänderung und ihr mathematischer Hintergrund)
Kommentar abgeben